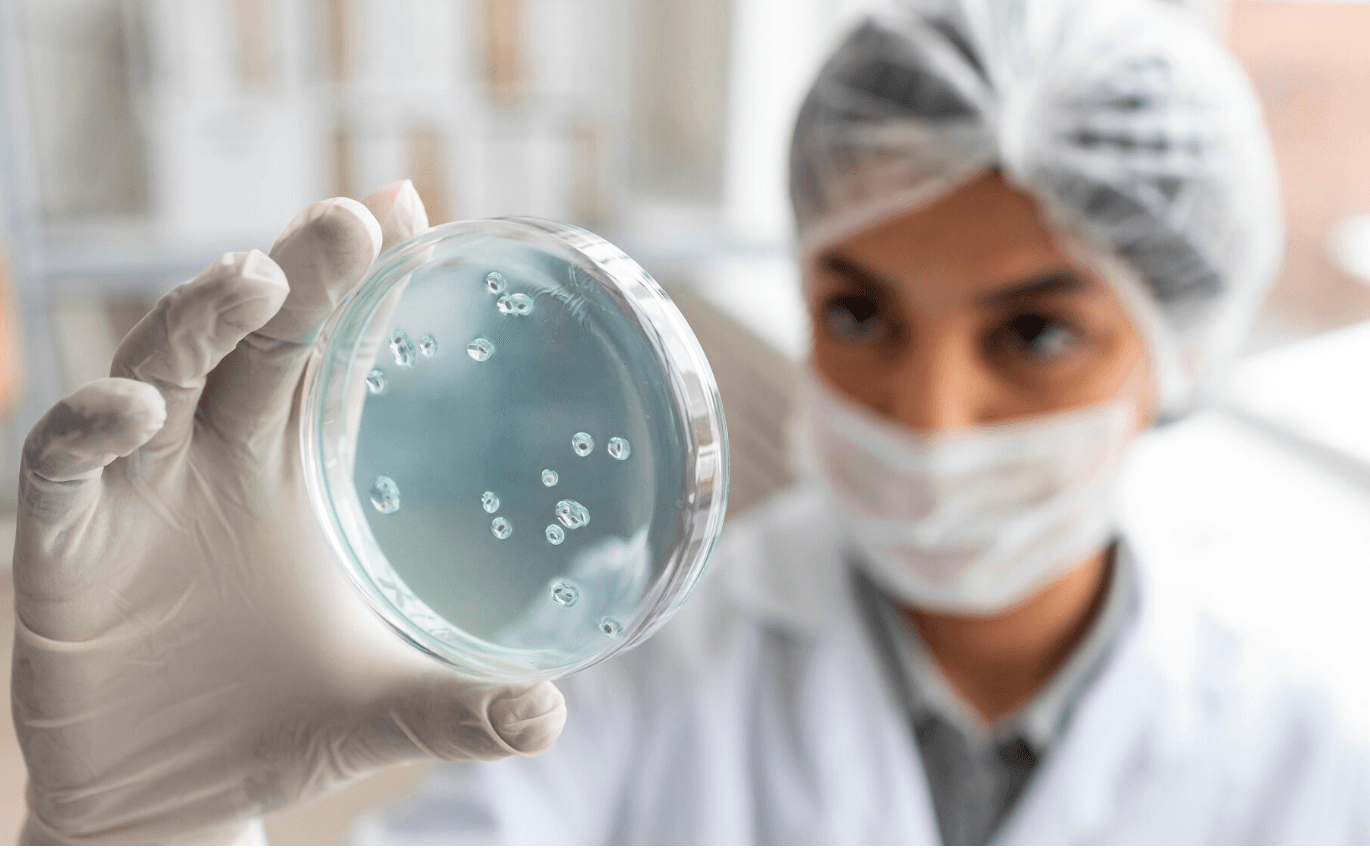
Иммунотерапия: как работает собственный иммунитет против опухоли

Иммунотерапия: как работает собственный иммунитет против опухоли
Представьте, что в вашем теле есть армия охранников — иммунная система. Обычно она охраняет от микробов и вирусов, но может распознавать и уничтожать и повреждённые клетки, которые стали раковыми. Проблема в том, что опухоль учится маскироваться: она отключает «сенсоры» иммунитета, создаёт вокруг себя щит из сигнальных молекул и «тормозит» рычаги атаки. Иммунотерапия — это набор методов, которые либо тренируют и усиливают собственные «солдаты», либо снимают с них тормоза, чтобы они смогли увидеть и убить опухолевые клетки.
Краткая история — от «я знаю, что это работает» до современных методов
Конец XIX — начало XX века: американский хирург Уильям Коули (William Coley) заметил, что у некоторых пациентов с опухолями регресс наступал после тяжёлой инфекции. Он вводил бактериальные препараты (так называемые «Coley’s toxins») и добивался уменьшения опухолей — это ранняя форма стимуляции иммунитета против рака.
1990-е — 2000-е: накопление знаний о сигнальных молекулах иммунитета. Ключевые открытия — молекулы-«тормоза» CTLA-4 и PD-1/PD-L1, которые позволяют опухоли «отключать» Т-лимфоциты. За их изучение в 2018 году Джеймс Эллисон и Тасуку Хонджо получили Нобелевскую премию. Открытие положило начало классу препаратов — ингибиторов иммунных чекпойнтов.
2010-е: вывод в клинику и одобрение новых платформ — в 2017 году первое одобренное клеточное генетическое лечение (CAR-T, tisagenlecleucel / Kymriah) для некоторых лейкемий; далее — рост числа одобрений для разных типов опухолей.
Какие основные виды иммунотерапии существуют (и от чего это зависит)
Ингибиторы иммунных чекпойнтов (PD-1, PD-L1, CTLA-4) — «снимают тормоза» с Т-клеток. Применяются при множестве солидных опухолей (меланома, немелкоклеточный рак лёгкого — NSCLC, почки, мочевой пузырь, некоторые желудочно-кишечные, опухоли головы и шеи, Ходжкинская лимфома и др.).
Клеточная терапия (CAR-T) — перерабатывают Т-клетки пациента генетически так, чтобы они распознавали специфический белок на опухоли. Эффективна при некоторых видах В-клеточных лимфом и лейкемий; активно тестируется для солидных опухолей.
Вакцины против рака — не те профилактические вакцины от инфекций, а терапевтические вакцины, которые учат иммунитет распознавать опухолевые антигены (например, вакцины на основе неоантигенов). Разработка активно идёт, многие платформы в клиниках.
Биспецифные антитела, адъюванты, клеточные продукты (Т-NK-клетки, модифицированные NK-клетки) и комбинации с традиционной терапией (химио/таргет).
Тип терапии и её успех зависят от: молекулярного профиля опухоли (наличие PD-L1, мутационной нагрузки, MSI-статуса), микросреды опухоли (иммунохолодная vs. иммуногорячая), общего состояния пациента и предыдущих лечений.
При каких раках иммунотерапия работает лучше, а где — нет
Часто эффективна (значимые клинические данные): меланома (революция — длительные ремиссии у части пациентов), NSCLC (особенно с высокой экспрессией PD-L1), почечно-клеточный рак, уротелиальные опухоли (мочевой пузырь), Ходжкинская лимфома, некоторые подтипы кишечника с MSI-high.
Ограниченная эффективность: многие солидные «иммунохолодные» опухоли (некоторые подтипы панкреатита/панкреатического рака, большинство случаев глиобластомы) — в них иммунная система «не замечает» опухоль или в неё не может проникнуть. Активно ищут комбинации и способы «разогреть» такую микросреду.
Важно: даже при опухолях, где иммунотерапия формально «работает», ответ получают далеко не все пациенты — существуют биомаркеры и алгоритмы отбора, но предсказание ответа остаётся активной задачей.
Цифры: масштаб и динамика (мир и Россия)
Мировая картина. Оценки показывают бурный рост рынка и применения ингибиторов чекпойнтов: доля пациентов, которые могут быть потенциально «квалифицированы» для ИКИ (immune checkpoint inhibitors), резко выросла за последние годы — по оценкам, охват показаний для ИКИ вырос с единичных процентов в 2011 до десятков процентов к 2023 (в одних исследованиях приводят цифры порядка 20–55% в зависимости от критериев: кто «имеет показание» и кто потенциально ответит). Это отражает и расширение клинических показаний, и стратегий комбинаций.
Рынок: по отраслевым отчётам, рынок ингибиторов чекпойнтов и иммунотерапии оценивается сейчас десятками миллиардов долларов (оценки 2023–2025: ~$48–58 млрд для чекпойнтов в 2023–2025 гг.), с сильным прогнозируемым ростом. Это косвенно говорит о широкой клинической и коммерческой экспансии.
Россия. Данные по РФ менее агрегированы в открытом доступе, но публикации последних лет показывают: увеличивается количество клинических испытаний с ИКИ и CAR-T, растёт реальное применение ИКИ в ведущих онкоцентрах (Москва, Санкт-Петербург и др.), появляются отечественные исследования по сочетаниям и неоадъювантному использованию. В ряде российских работ 2023–2025 гг. анализируются сотни–тысячи случаев лечения ИКИ в реальной практике. Однако доступ и покрытие (реimbursement) остаются ограничивающими факторами для широкой доступности во всей стране.
Что появилось нового за последний год (≈ 2024–2025)
Коротко о трендах и заметных новинках:
Неоадъювантная иммунотерапия (лечение до операции) для ряда локальных опухолей даёт впечатляющие ответы — в некоторых случаях опухоль уменьшается настолько, что операция становится легче или менее травматичной.
Персонализированные вакцины и неоантигенные подходы — клинические испытания показывают жизнеспособность идеи: создавать вакцину по уникальным мутациям опухоли конкретного пациента.
Улучшенные алгоритмы предсказания ответа на ИКИ — в 2024–2025 годах появились публикации с применением машинного обучения к рутинным тестам крови и профилю опухоли для прогнозирования ответа. Это поможет точнее выбирать пациентов.
CAR-T для солидных опухолей и новые клеточные платформы — активные исследования биспецификов, модифицированных NK-клеток и следующих поколений CAR-T, а также попытки уменьшить токсичность и стоимость.
Риски и побочные эффекты — почему важно не «переполучить» иммунитет
Иммунотерапия может дать «длительные» ответы, но у неё есть специфические побочные эффекты: аутоиммунные реакции (колит, пневмонит, гормональные нарушения и др.), цитокиновый синдром при CAR-T. Иногда побочные явления требуют прекращения лечения и гормональной терапии. Поэтому выбор и мониторинг — критически важны.
Выводы — что важно знать простым языком
Иммунотерапия — это не одна «таблетка», а множество подходов, которые учат или «снимают тормоза» с иммунитета, чтобы он боролся с раком.
История идёт от наблюдений Коули до современных чекпойнтов и CAR-T; ключевые открытия получили Нобелевку и перевели идею в практику.
Работает особенно хорошо при определённых опухолях (меланома, NSCLC, RCC, некоторые лимфомы), но далеко не у всех и не при всех типах — поэтому нужны биомаркеры и персонализация.
За последние 2–3 года применение и исследования активнее растут: расширяются показания, появляются персонализированные вакцины, лучше становятся алгоритмы отбора пациентов и развиваются новые клеточные терапии.
В России иммунотерапия внедряется и развивается, но доступность и покрытие остаются узким местом — ведущие центры уже активно применяют и тестируют новинки.